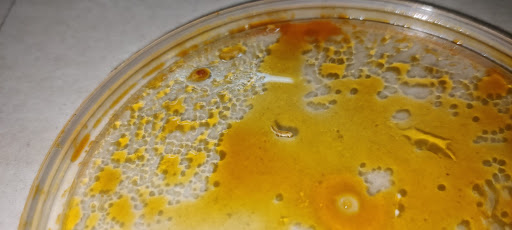

A2b veg restaurant things to do, attractions, restaurants, events info and trip planning

Basic Info
A2b veg restaurant
No: 172/173, Velachery - Tambaram Main Rd, Aarthi Nagar, Selaiyur, Chennai, Tamil Nadu 600073, India
3.9(403)
Save
spot
spot
Ratings & Description
Info
attractions: , restaurants: Adyar Ananda Bhavan - A2B, Tarts The Eaters Club, Chai Waale Selaiyur, McRennett Cakes, Teabon, Nikkah Biryani, Quality Restaurant, Junior kuppanna, Selaiyur, Frozen Bottle - Milkshakes, Desserts And Ice Cream, Cake Waves Selaiyur, local businesses: Ganga sweets, Maams Cake
 Learn more insights from Wanderboat AI.
Learn more insights from Wanderboat AI.Website
aabsweets.com
Plan your stay

Pet-friendly Hotels in Tamil Nadu
Find a cozy hotel nearby and make it a full experience.

Affordable Hotels in Tamil Nadu
Find a cozy hotel nearby and make it a full experience.

The Coolest Hotels You Haven't Heard Of (Yet)
Find a cozy hotel nearby and make it a full experience.

Trending Stays Worth the Hype in Tamil Nadu
Find a cozy hotel nearby and make it a full experience.
Reviews
Live events

A Day with a Local - Cooking, Temple Visit and Fun
Sun, Mar 1 • 9:30 AM
Chennai, Tamil Nadu, 600033, India
View details

Musical Walk along Chennais Marina Beach
Sat, Feb 28 • 6:00 AM
Chennai, Tamil Nadu, 600009, India
View details

Explore Street Shopping and try Local Food
Wed, Mar 4 • 11:00 AM
Chennai, Tamil Nadu, 600017, India
View details
Nearby restaurants of A2b veg restaurant
Adyar Ananda Bhavan - A2B
Tarts The Eaters Club
Chai Waale Selaiyur
McRennett Cakes
Teabon
Nikkah Biryani
Quality Restaurant
Junior kuppanna, Selaiyur
Frozen Bottle - Milkshakes, Desserts And Ice Cream
Cake Waves Selaiyur

Adyar Ananda Bhavan - A2B
3.8
(3.3K)
Closed
Click for details

Tarts The Eaters Club
4.2
(238)
Closed
Click for details

Chai Waale Selaiyur
3.8
(48)
Open until 11:00 PM
Click for details

McRennett Cakes
4.1
(442)
Closed
Click for details
Nearby local services of A2b veg restaurant
Ganga sweets
Maams Cake

Ganga sweets
4.1
(445)
Click for details

Maams Cake
4.7
(147)
Click for details